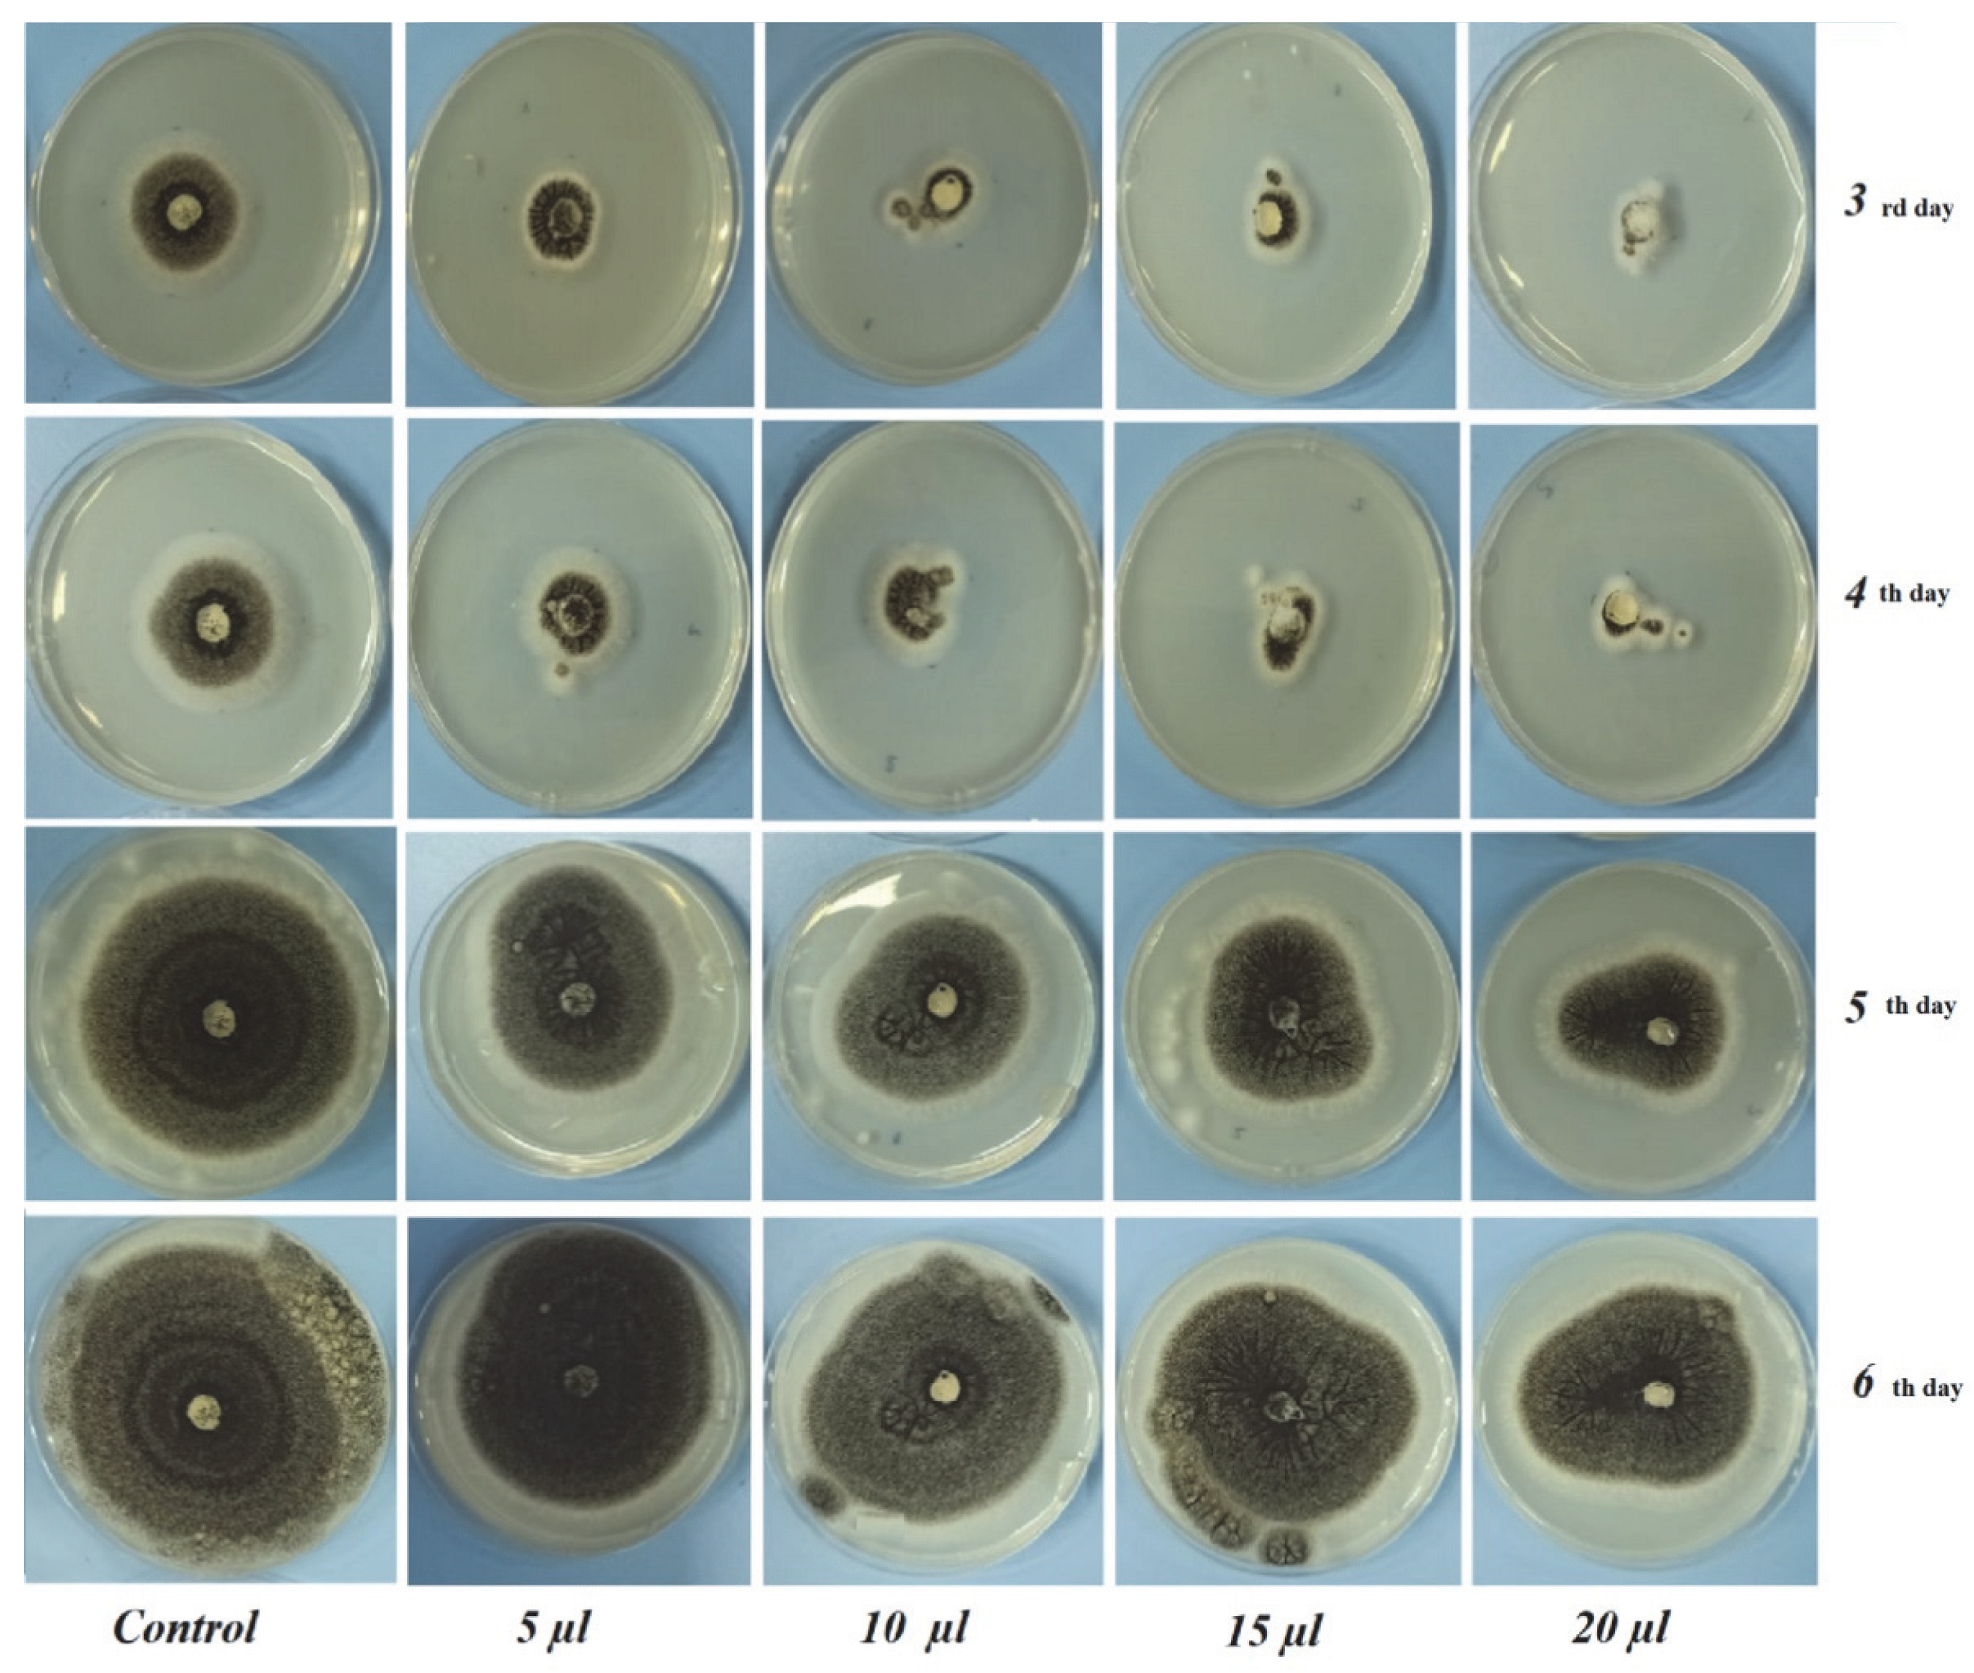
Foods 12 00203 g002 Foods 12 00203 g002
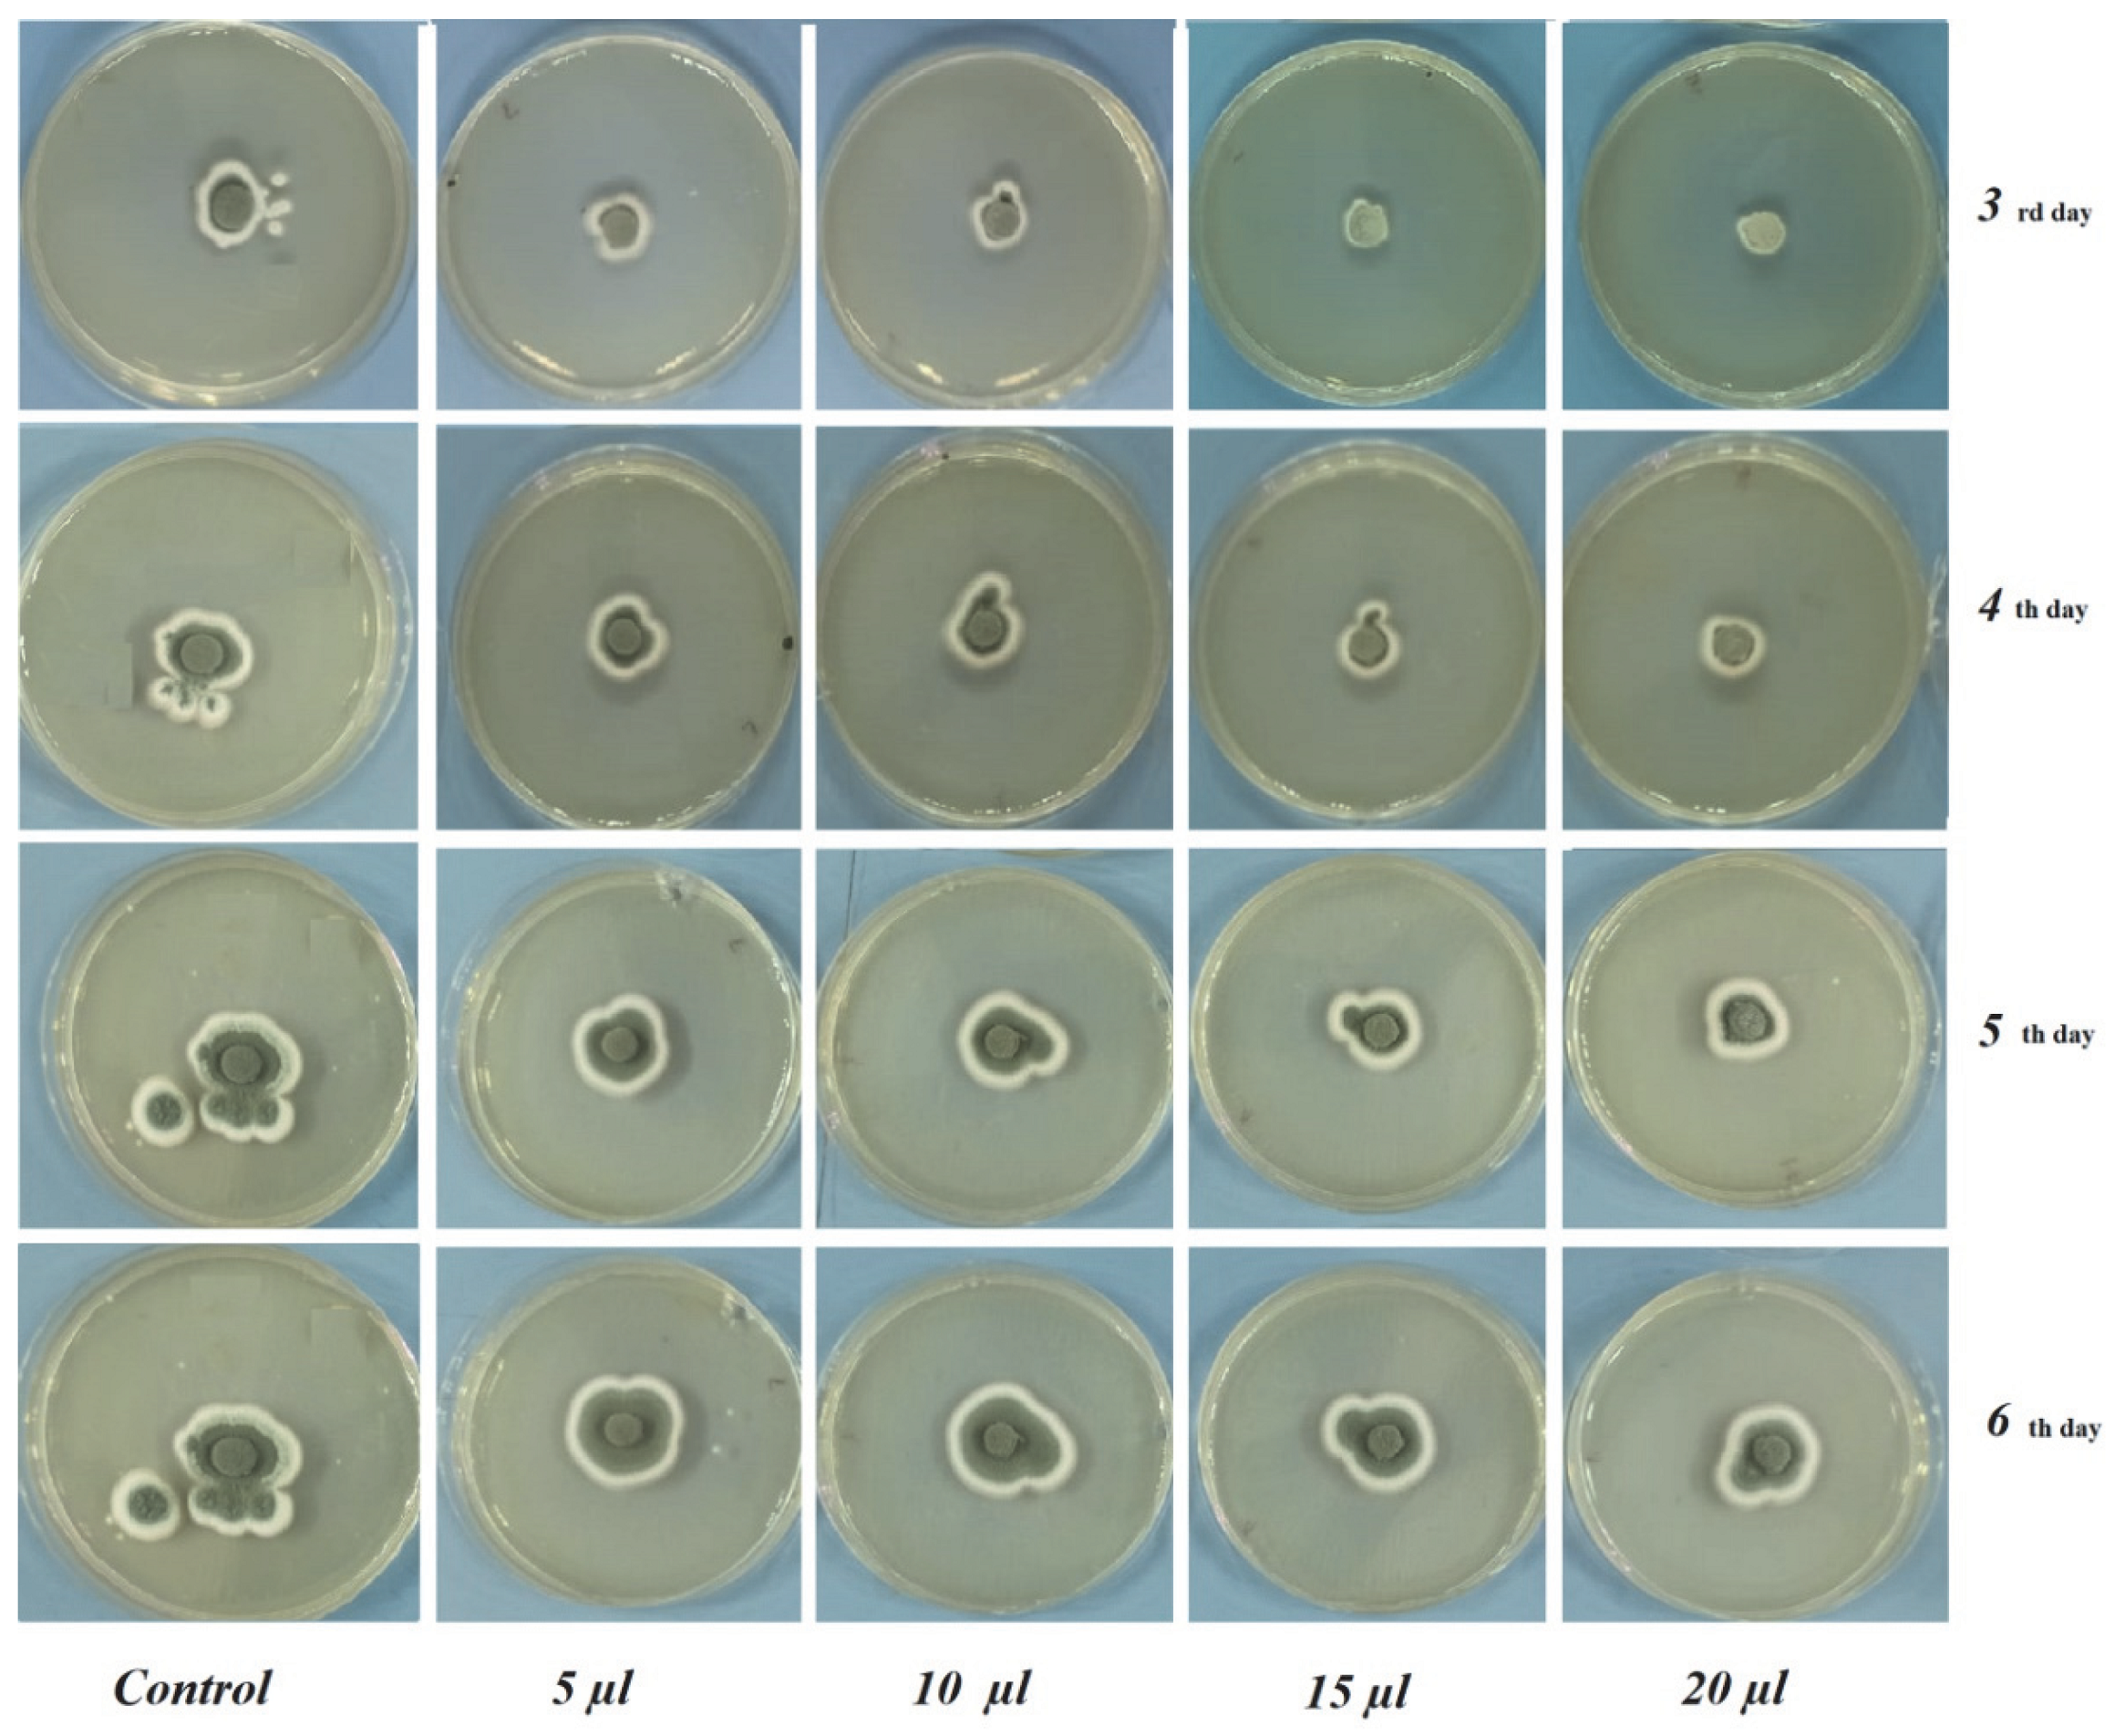
Foods 12 00203 g003 Foods 12 00203 g003

Determination of the Antifungal, Antibacterial Activity and Volatile Compound Composition of Citrus bergamia Peel Essential Oil
Abstract
1. Introduction
2. Materials and Methods
2.1. Essential Oil and Chemicals
2.2. Isolation and Identification of Pathogenic Fungi
2.3. In Vitro Antifungal Assay
2.4. Linear Polynomial Contrast
2.5. Determination of Antibacterial Activity
2.6. Statistical Analysis
2.7. FTIR Data Acquisition
2.8. GC–MS Analysis
2.8.1. C. bergamia EO Extraction from Fresh Peels
2.8.2. GC–MS Data Acquisition of C. bergamia EO
3. Results
3.1. Antibacterial Activity Assay
3.2. In Vitro Antifungal Assay
3.3. FTIR Characterization of C. bergamia EO
3.4. GC–MS Characterization of C. bergamia EO
4. Discussion
5. Conclusions
Author Contributions
Funding
Data Availability Statement
Acknowledgments
Conflicts of Interest
References
- Raut, J.S.; Karuppayil, S.M. A status review on the medicinal properties of essential oils. Ind. Crops Prod. 2014, 62, 250–264. [Google Scholar] [CrossRef]
- Cebi, N.; Taylan, O.; Abusurrah, M.; Sagdic, O. Detection of orange essential oil, isopropyl myristate, and benzyl alcohol in lemon essential oil by ftir spectroscopy combined with chemometrics. Foods 2021, 10, 27. [Google Scholar] [CrossRef] [PubMed]
- Hyldgaard, M.; Mygind, T.; Meyer, R.L. Essential oils in food preservation: Mode of action, synergies, and interactions with food matrix components. Front. Microbiol. 2012, 3, 12. [Google Scholar] [CrossRef]
- El Ouadi, Y.; Manssouri, M.; Bouyanzer, A.; Majidi, L.; Bendaif, H.; Elmsellem, H.; Shariati, M.A.; Melhaoui, A.; Hammouti, B. Essential oil composition and antifungal activity of Melissa officinalis originating from north-Est Morocco, against postharvest phytopathogenic fungi in apples. Microb. Pathog. 2017, 107, 321–326. [Google Scholar] [CrossRef] [PubMed]
- Kordali, S.; Cakir, A.; Mavi, A.; Kilic, H.; Yildirim, A. Screening of chemical composition and antifungal and antioxidant activities of the essential oils from three Turkish Artemisia species. J. Agric. Food Chem. 2005, 53, 1408–1416. [Google Scholar] [CrossRef]
- Yilmaz, A.; Bozkurt, F.; Cicek, P.K.; Dertli, E.; Durak, M.Z.; Yilmaz, M.T. A novel antifungal surface-coating application to limit postharvest decay on coated apples: Molecular, thermal and morphological properties of electrospun zein–nanofiber mats loaded with curcumin. Innov. Food Sci. Emerg. Technol. 2016, 37, 74–83. [Google Scholar] [CrossRef]
- Vehapi, M.; Koçer, A.T.; Yılmaz, A.; Özçimen, D. Investigation of the antifungal effects of algal extracts on apple-infecting fungi. Arch. Microbiol. 2020, 202, 455–471. [Google Scholar] [CrossRef]
- Singh, S.; Singh, N.; Kumar, V.; Datta, S.; Wani, A.B.; Singh, D.; Singh, K.; Singh, J. Toxicity, monitoring and biodegradation of the fungicide carbendazim. Environ. Chem. Lett. 2016, 14, 317–329. [Google Scholar] [CrossRef]
- Kulkarni, S.A.; Sellamuthu, P.S.; Nagarajan, S.K.; Madhavan, T.; Sadiku, E.R. Antifungal activity of wild bergamot (Monarda fistulosa) essential oil against postharvest fungal pathogens of banana fruits. S. Afr. J. Bot. 2022, 144, 166–174. [Google Scholar] [CrossRef]
- Lee, J.E.; Seo, S.M.; Huh, M.J.; Lee, S.C.; Park, I.K. Reactive oxygen species mediated-antifungal activity of cinnamon bark (Cinnamomum verum) and lemongrass (Cymbopogon citratus) essential oils and their constituents against two phytopathogenic fungi. Pestic. Biochem. Physiol. 2020, 168, 104644. [Google Scholar] [CrossRef]
- Marzocchi, S.; Baldi, E.; Crucitti, M.C.; Toselli, M.; Caboni, M.F. Effect of harvesting time on volatile compounds composition of bergamot (Citrus × bergamia) essential oil. Flavour Fragr. J. 2019, 34, 426–435. [Google Scholar] [CrossRef]
- Yilmaz, A.; Ermis, E.; Boyraz, N. Investigation of in vitro and in vivo antifungal activities of different plant essential oils against postharvest apple rot diseases-Colletotrichum gloeosporioides, Botrytis cinerea and Penicillium expansum. J. Food Saf. Food Qual. 2016, 67, 122–131. [Google Scholar]
- Vehapi, M.; Yilmaz, A.; Özçimen, D. Antifungal Activities of Chlorella vulgaris and Chlorella minutissima microalgae cultivated in bold basal medium, wastewater and tree extract water against Aspergillus niger and antifungal activities of Chlorella vulgaris and Chlorella minutissima microalgae cultivated in bold basal medium, wastewater and tree extract water against Aspergillus niger and Fusarium oxysporum. Rom. Biotechnol. Lett. 2018, 1, 1–8. [Google Scholar] [CrossRef]
- Zhang, J.; Ma, S.; Du, S.; Chen, S.; Sun, H. Antifungal activity of thymol and carvacrol against postharvest pathogens Botrytis cinerea. J. Food Sci. Technol. 2019, 56, 2611–2620. [Google Scholar] [CrossRef] [PubMed]
- Marotta, S.M.; Giarratana, F.; Parco, A.; Neri, D.; Ziino, G.; Giuffrida, A.; Panebianco, A. Evaluation of the antibacterial activity of bergamot essential oils on different Listeria monocytogenes strains. Ital. J. Food Saf. 2016, 5, 3. [Google Scholar] [CrossRef] [PubMed]
- Taylan, O.; Cebi, N.; Sagdic, O. Rapid screening of Mentha spicata essential oil and l-menthol in Mentha piperita essential oil by atr-ftir spectroscopy coupled with multivariate analyses. Foods 2021, 10, 202. [Google Scholar] [CrossRef]
- Bounaas, K.; Bouzidi, N.; Daghbouche, Y.; Garrigues, S.; de la Guardia, M.; El Hattab, M. Essential oil counterfeit identification through middle infrared spectroscopy. Microchem. J. 2018, 139, 347–356. [Google Scholar] [CrossRef]
- Berechet, M.D.; Calinescu, I.; Stelescu, M.D.; Manaila, E.; Craciun, G.; Purcareanu, B.; Mihaiescu, D.E.; Rosca, S.; Fudulu, A.; Niculescu-Aron, I.G.; et al. Composition of the essential oil of Rosa damascena Mill. cultivated in Romania. Rev. Chim. 2015, 66, 1986–1991. [Google Scholar]
- Benoudjit, F.; Maameri, L.; Ouared, K.; History, A. Evaluation of the quality and composition of lemon (Citrus limon) peel essential oil from an Algerian fruit juice industry. Alger. J. Environ. Sci. Technol. 2020, 6, 1575–1581. [Google Scholar]
- Adams, R.P. Identification of Essential oil Components by Gas Chromatography/Mass Spectrometry, 4th ed.; Allured Publishing Corporation: Carol Stream, IL, USA, 2017. [Google Scholar]
- Thobunluepopi, P.; Udumsilp, J.; Piyo, A.; Khaengkhan, P. Screening for The antifungal activity of essential oils from bergamot oil (Citrus hystrix DC.) and tea tree oil (Melaleuca alternifolia) against economically rice pathogenic fungi: A driving force of organic rice cv. KDML 105 Production. Asian J. Food Agro-Ind. 2009, 2, 374–380. [Google Scholar]
- Fisher, K.; Phillips, C.A. The effect of lemon, orange and bergamot essential oils and their components on the survival of Campylobacter jejuni, Escherichia coli O157, Listeria monocytogenes, Bacillus cereus and Staphylococcus aureus in vitro and in food systems. J. Appl. Microbiol. 2006, 101, 1232–1240. [Google Scholar] [CrossRef] [PubMed]
- Cirmi, S.; Bisignano, C.; Mandalari, G.; Navarra, M. Anti-infective potential of C. bergamia Risso et Poiteau (bergamot) derivatives: A systematic review. Phyther. Res. 2016, 1411, 1404–1411. [Google Scholar] [CrossRef] [PubMed]
- Oussalah, M.; Caillet, S.; Lacroix, M. Mechanism of action of Spanish oregano, Chinese cinnamon, and savory essential oils against cell membranes and walls of Escherichia coli O157:H7 and Listeria monocytogenes. J. Food Prot. 2006, 69, 1046–1055. [Google Scholar] [CrossRef]
- Caputo, L.; Cornara, L.; Bazzicalupo, M.; De Francesco, C.; De Feo, V.; Trombetta, D.; Smeriglio, A. Chemical composition and biological activities of essential oils from peels of three Citrus species. Molecules 2020, 25, 1890. [Google Scholar] [CrossRef] [PubMed]
- Nabiha, B.; Kachouri, F.; Herve, C. Chemical Composition of Bergamot (C. bergamia Risso) Essential oil chemical composition of bergamot (C. bergamia Risso) essential oil obtained by hydrodistillation. J. Chem. Chem. Eng. 2010, 4, 60–62. [Google Scholar]
- Radulovic, N.S.; Blagojevic, P.D.; Stojanovic-Radic, Z.Z.; Stojanovic, N.M. Antimicrobial plant metabolites: Structural diversity and mechanism of action. Curr. Med. Chem. 2013, 20, 932–952. [Google Scholar]
- Oussalah, M.; Caillet, S.; Salmiéri, S.; Saucier, L.; Lacroix, M. Antimicrobial effects of alginate-based films containing essential oils on Listeria monocytogenes and Salmonella typhimurium present in bologna and ham. J. Food Prot. 2007, 70, 901–908. [Google Scholar] [CrossRef]
- Cebi, N.; Erarslan, A. Determination of the Chemical Fingerprint, Volatile Composition, Antibacterial and Antifungal Effects of Bergamot Essential oil. In Proceedings of the 6th International Academic Studies Congress, Online, 26–28 July 2021. [Google Scholar]

| Species | 0.5 µg/mL | 1 µg/mL | 2.5 µg/mL | 5 µg/mL |
|---|---|---|---|---|
| S. typhimurium | 9.25 ± 0.35 a | 10.87 ± 1.23 b | 11.50 ± 0.70 c | 11.50 ± 0.35 c |
| B. cereus | 8.50 ± 0.70 a | 12.00 ± 0.00 b | 12.50 ± 0.70 c | 12.50 ± 0.35 c |
| S. aureus | 10.00 ± 0.00 a | 10.50 ± 0.70 b | 10.50 ± 2.12 b | 11.50 ± 0.00 c |
| E. coli | 10.00 ± 0.00 a | 11.50 ± 0.70 b | 12.50 ± 0.70 c | 12.50 ± 0.00 c |
| L. monocytogenes | 10.00 ± 0.00 a | 12.75 ± 0.35 b | 13.00 ± 0.70 b | 13.50 ± 0.70 c |
| Incubation Days | Control | 5 µL | 10 µL | 15 µL | 20 µL |
|---|---|---|---|---|---|
| 3 | 41.66 ± 1.25 a | 31.00 ± 3.04 b | 27.83 ± 1.60 c | 22.75 ± 0.35 d | 19.83 ± 1.04 e |
| 4 | 58.66 ± 1.52 a | 46.5 ± 2.12 b | 43.25 ± 1.76 c | 40.00 ± 0.00 d | 34.50 ± 0.70 e |
| 5 | 77.5 ± 3.53 a | 64.00 ± 2.82 b | 59.5 ± 2.12 c | 57.75 ± 0.35 c | 50.00 ± 1.41 d |
| 6 | 90.00 ± 0.00 a | 78.00 ± 0.00 b | 77.00 ± 2.82 b | 75.00 ± 0.00 c | 67.25 ± 0.35 d |
| Incubation Days | Control | 5 µL | 10 µL | 15 µL | 20 µL |
|---|---|---|---|---|---|
| 3 | 19.00 ± 0.00 a | 19.50 ± 1.50 b | 17.50 ± 0.00 c | 14.66 ± 0.76 d | 13.83 ± 0.76 e |
| 4 | 25.50 ± 0.35 a | 23.83 ± 2.56 b | 22.50 ± 0.00 c | 18.33 ± 0.76 | 17.66 ± 0.57 e |
| 5 | 30.75 ± 2.47 a | 28.00 ± 2.00 b | 26.50 ± 0.00 c | 23.83 ± 1.60 c | 21.83 ± 0.76 e |
| 6 | 45.50 ± 2.12 a | 32.00 ± 2.82 b | 31.50 ± 0.00 b | 27.00 ± 0.00 c | 26.16 ± 0.76 d |
| Content (%) | Chemical Name | RT a | RI b |
|---|---|---|---|
| 0.14 ± 0.02 | α-Thujene | 8.541 | 924 |
| 0.57 ± 0.02 | α-Pinene | 8.701 | 932 |
| 0.45 ± 0.05 | Sabinene | 9.615 | 969 |
| 2.51 ± 0.03 | β-Pinene | 9.698 | 974 |
| 1.18 ± 0.07 | Myrcene | 9.983 | 988 |
| 0.04 ± 0.01 | Octanal | 10.234 | 998 |
| 0.16 ± 0.09 | α-Terpinene | 10.567 | 1014 |
| 17.06 ± 0.06 | Limonene | 10.947 | 1024 |
| 0.2 ± 0.04 | Z-β-Ocimene | 11.021 | 1032 |
| 0.54 ± 0.05 | E-β-Ocimene | 11.277 | 1044 |
| 4.11 ± 0.06 | γ-Terpinene | 11.604 | 1054 |
| 0.39 ± 0.06 | Terpinolene | 12.389 | 1086 |
| 46.34 ± 0.02 | Linalool | 13.046 | 1095 |
| 0.28 ± 0.03 | Trans-sabinene hydrate | 15.103 | 1098 |
| 2.41 ± 0.02 | Exo-fenchol | 15.522 | 1118 |
| 0.05 ± 0.09 | Decanal | 15.819 | 1201 |
| 0.08 ± 0.05 | Acetic acid | 15.969 | 1211 |
| 1.23 ± 0.01 | Nerol | 16.569 | 1227 |
| 0.56 ± 0.03 | Z-citral | 16.903 | 1235 |
| 17.69 ± 0.06 | Linalyl acetate | 17.414 | 1254 |
| 0.80 ± 0.05 | Dimethoxy-(E)-citral | 17.757 | 1338 |
| 0.95 ± 0.05 | Neryl acetate | 20.306 | 1359 |
| 1.13 ± 0.04 | Geranyl acetate | 20.822 | 1379 |
| 0.30 ± 0.05 | Z-Caryophyllene | 21.954 | 1408 |
| 0.27 ± 0.06 | Cis-α-Bergamotene | 22.290 | 1411 |
| 0.05 ± 0.07 | Z-β -Farnesene | 22.755 | 1440 |
| 0.36 ± 0.08 | β-Bisabolene | 24.126 | 1505 |
| Total: 99.85 | Total | ||
| 27.35 | Monoterpene hydrocarbons | ||
| 71.52 | Oxygenated monoterpenes | ||
| 0.98 | Sesquiterpene hydrocarbons | ||
| 0 | Oxygenated sesquiterpenes |
Disclaimer/Publisher’s Note: The statements, opinions and data contained in all publications are solely those of the individual author(s) and contributor(s) and not of MDPI and/or the editor(s). MDPI and/or the editor(s) disclaim responsibility for any injury to people or property resulting from any ideas, methods, instructions or products referred to in the content. |
© 2023 by the authors. Licensee MDPI, Basel, Switzerland. This article is an open access article distributed under the terms and conditions of the Creative Commons Attribution (CC BY) license (https://creativecommons.org/licenses/by/4.0/).
Share and Cite
Cebi, N.; Erarslan, A. Determination of the Antifungal, Antibacterial Activity and Volatile Compound Composition of Citrus bergamia Peel Essential Oil. Foods 2023, 12, 203. https://doi.org/10.3390/foods12010203
Cebi N, Erarslan A. Determination of the Antifungal, Antibacterial Activity and Volatile Compound Composition of Citrus bergamia Peel Essential Oil. Foods. 2023; 12(1):203. https://doi.org/10.3390/foods12010203
Chicago/Turabian StyleCebi, Nur, and Azime Erarslan. 2023. "Determination of the Antifungal, Antibacterial Activity and Volatile Compound Composition of Citrus bergamia Peel Essential Oil" Foods 12, no. 1: 203. https://doi.org/10.3390/foods12010203
APA StyleCebi, N., & Erarslan, A. (2023). Determination of the Antifungal, Antibacterial Activity and Volatile Compound Composition of Citrus bergamia Peel Essential Oil. Foods, 12(1), 203. https://doi.org/10.3390/foods12010203
